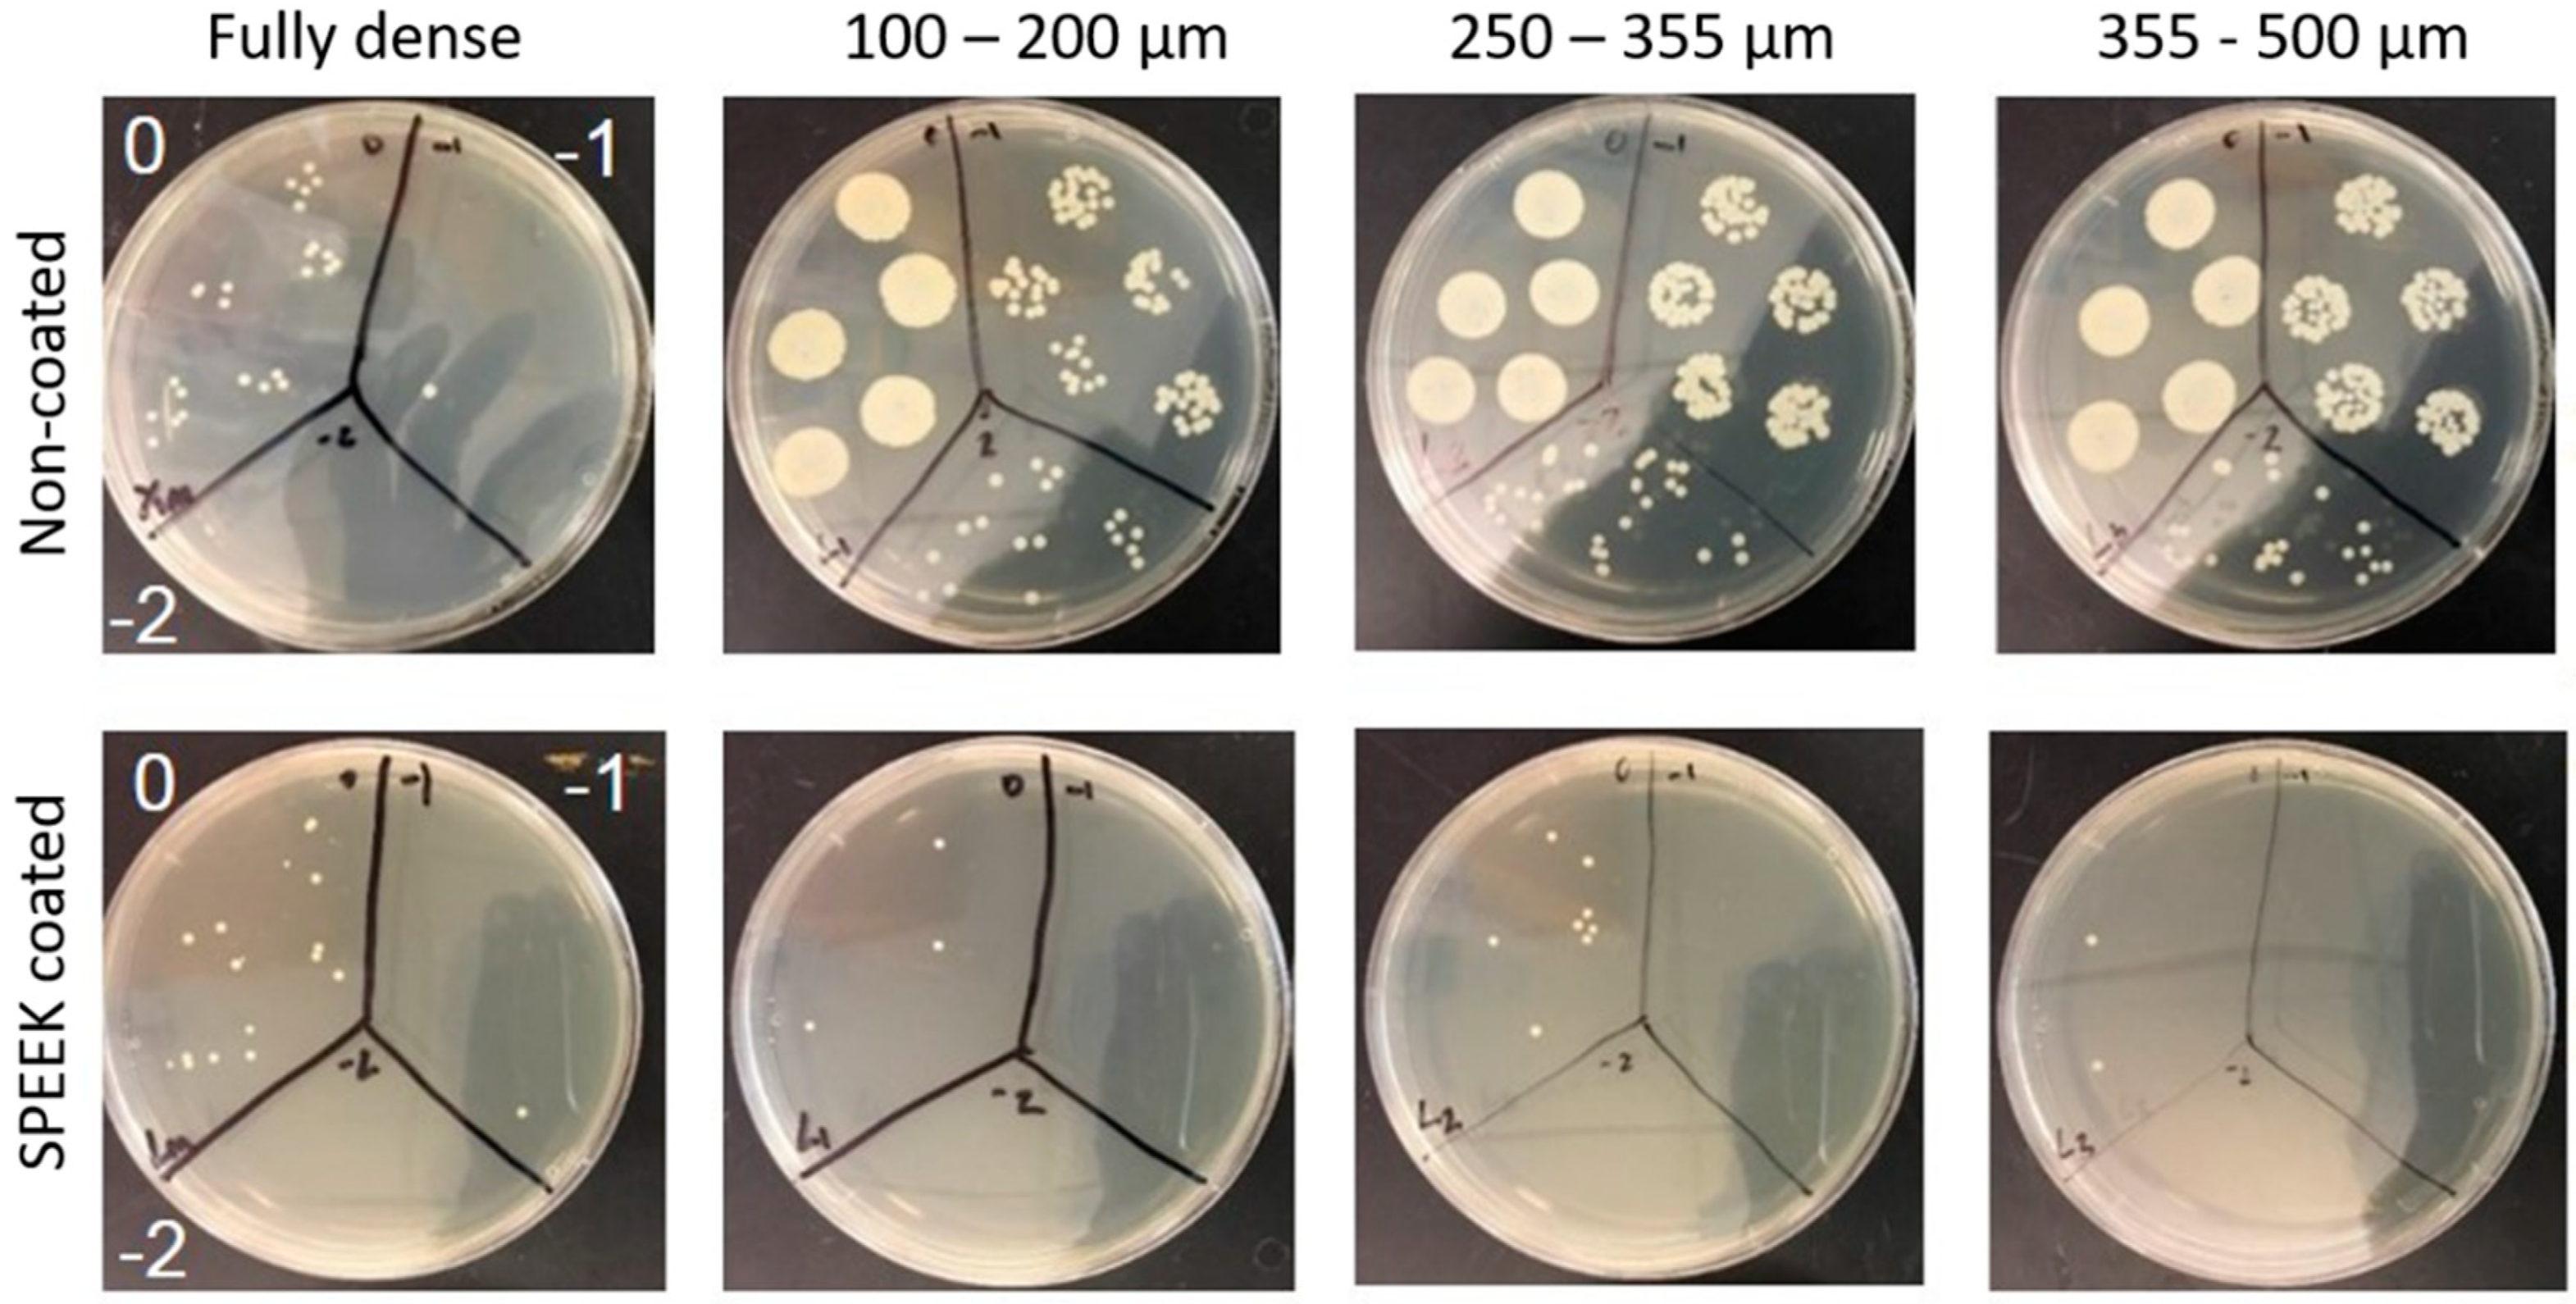
Metals 09 00995 g012

Porous Titanium Surfaces to Control Bacteria Growth: Mechanical Properties and Sulfonated Polyetheretherketone Coatings as Antibiofouling Approaches
Abstract
:1. Introduction
2. Materials and Methods
2.1. Fabrication of Fully-Dense and Porous Titanium Substrates
2.2. Fabrication and Deposition of the SPEEK Coating
2.3. Microstructural and Mechanical Characterization of the c.p. Ti Substrates
2.4. Evaluation of Bacteria Behavior
2.5. Statistical Analysis
3. Results and Discussion
3.1. Titanium Substrate Characterization: Microstructural and Mechanical Properties
- For the same maximum load, the penetration depth and elastic recovery was higher for porous samples (see Table 3), particularly for the substrate with a lower mean free path between the pores (higher effect of the porosity). The direct relationship between porosity and elastic recovery is widely accepted in the literature [38,52].
- Regardless of the type of substrate, the micromechanical properties depended on the value of the applied load and the mode of application of these local phenomena of micro plasticity and hardening. The influence of the tip of the indenter, the surface roughness, the sensitivity of the load cell and the linear variable differential transformer, etc., must also be considered.
- Independent of the maximum applied load, micro-hardness and stiffness increased with the mean free path and, thus, with the size of the Ti matrix where indentation was performed. This fact means that the influence of porosity was less pronounced in micro-mechanical properties compared to the fully-dense c.p. Ti substrates (which had a porosity of 2.9 vol. %).
- It should be noticed that, although the values of hardness and stiffness differed, that a similar tendency was observed: Both properties increased with the mean free path in porous Ti substrates, but they were always lower than in the case of the fully-dense c.p. Ti substrate.
- The differences observed for the stiffness values could be associated with the volume of material involved in each type of test (the influence of the porosity and plasticity phenomena), deformation speed, and/or test limitations (rigidity of testing machine, precision, etc.).
- The inverse tendencies of the micro-hardness values and E with the applied load in the dynamic tests was generally expected, as were the values obtained in the plateau zone (corroborant the role of porosity), as was discussed above.
3.2. Evaluation of Bacterial Behavior on Fully and Porous Substrates with and without SPEEK Coating
4. Conclusions
Author Contributions
Funding
Acknowledgments
Conflicts of Interest
References
- Kurtz, S.M.; Ong, K.L.; Lau, E.; Bozic, K.J.; Berry, D.; Parvizi, J. Prosthetic joint infection risk after TKA in the Medicare population. Clin. Orthop. Relat. Res. 2010, 468, 52–56. [Google Scholar] [CrossRef] [PubMed]
- Lafaurie, G.I.; Sabogal, M.A.; Castillo, D.M.; Rincón, M.V.; Gómez, L.A.; Lesmes, Y.A.; Chambrone, L. Microbiome and microbial biofilm profiles of peri-implantitis: A systematic review. J. Periodontol. 2017, 88, 1066–1089. [Google Scholar] [CrossRef] [PubMed]
- Derks, J.; Tomasi, C. Peri-implant health and disease. A systematic review of current epidemiology. J. Clin. Periodontol. 2015, 42, S158–S171. [Google Scholar] [CrossRef] [PubMed]
- Liu, R.; Tang, Y.; Zeng, L.; Zhao, Y.; Ma, Z.; Sun, Z.; Ren, L.; Yang, K. In vitro and in vivo studies of anti-bacterial copper-bearing titanium alloy for dental application. Dent. Mater. 2018, 34, 1112–1126. [Google Scholar] [CrossRef] [PubMed]
- Zhao, L.; Wang, H.; Cu, L.; Zhang, W.; Ni, H.; Zhang, Y.; Wu, Z.; Chu, P.K. Antibacterial nano-structured titania coating incorporated with silver nanoparticles. Biomaterials 2011, 32, 5706–5716. [Google Scholar] [CrossRef] [PubMed]
- Cheng, L.; Weir, M.D.; Xu, H.H.; Antonucci, J.M.; Kraigsley, A.M.; Lin, N.J.; Lin-Gibson, S.; Zhou, X. Antibacterial amorphous calcium phosphate nanocomposites with a quaternary ammonium dimethacrylate and silver nanoparticles. Dent. Mater. 2012, 28, 561–572. [Google Scholar] [CrossRef] [PubMed] [Green Version]
- Dhir, S. Biofilm and dental implant: The microbial link. J. Indian Soc. Periodontol. 2013, 17, 5–11. [Google Scholar] [CrossRef] [PubMed]
- Soloaga, R.; Corso, A.; Gagetti, P.; Faccone, D.; Galas, M. Detección de meticilino-resistencia en Staphylococcus aureus: Comparación de métodos convencionales y aglutinación con mrsa-Screen latex. Rev. Argent. Microbiol. 2004, 36, 36–40. [Google Scholar] [PubMed]
- Gleva, M.; Arxé, D. Do you know the MARSA? Do you know how to act against MARSA? (original title: ¿Conoces el MARSA? ¿Sabes cómo actuar delante de un MARSA?). El Peu 2005, 25, 126–131. [Google Scholar]
- Montero, M. Pseudomonas Aeruginosa Multiresistente: Aspectos Epidemiológicos, Clínicos y Terapéuticos. Ph.D. Thesis, Universidad Autonoma de Barcelona, Barcelona, Spain, 2012. [Google Scholar]
- Bevilacqua, L.; Milan, A.; Del Lupo, V.; Maglione, M.; Dolzani, L. Biofilms developed on dental implant titanium surfaces with different roughness: Comparison between in vitro and in vivo studies. Curr. Microbiol. 2018, 75, 766–772. [Google Scholar] [CrossRef]
- Kunčická, N.; Kocich, R.; Lowe, T.C. Advances in metals and alloys for joint replacement. Prog. Mater. Sci. 2017, 88, 232–280. [Google Scholar] [CrossRef]
- Niinomi, M. Mechanical biocompatibilities of titanium alloys for biomedical applications. J. Mech. Behav. Biomed. Mater. 2008, 1, 30–42. [Google Scholar] [CrossRef] [PubMed]
- Torres, Y.; Pavón, J.J.; Rodríguez-Ortiz, J.A. Processing and characterization of porous titanium for implants by using NaCl as space holder. J. Mater. Process. Technol. 2012, 212, 1061–1069. [Google Scholar] [CrossRef]
- Torres, Y.; Pavón, J.J.; Nieto, I.; Rodríguez-Ortiz, J.A. Conventional powder metallurgy process and characterization of porous titanium for biomedical applications. Metall. Mater. Trans. B Process. Metall. Mater. Process. Sci. 2011, 42, 891–900. [Google Scholar] [CrossRef]
- Muñoz, S.; Pavón, J.J.; Rodríguez-Ortiz, J.A.; Civantos, A.; Allain, J.P.; Torres, Y. On the influence of space holder in the development of porous titanium implants: Mechanical, computational and biological evaluation. Mater. Charact. 2015, 108, 68–78. [Google Scholar] [CrossRef]
- Jurczyk, M.U.; Jurczyk, K.; Miklaszewski, A.; Jurczyk, M. Nanostructured titanium-45S5 Bioglass scaffold composites for medical applications. Mater. Des. 2011, 32, 4882–4889. [Google Scholar] [CrossRef]
- Torres, Y.; Rodrıguez-Ortiz, J.A.; Arias, S.; Echeverry, M.; Robledo, S.; Amigo, V.; Pavón, J.J. Processing, characterization and biological testing of porous titanium obtained by space-holder technique. J. Mater. Sci. 2012, 47, 6565–6576. [Google Scholar] [CrossRef]
- Pałka, K.; Pokrowiecki, R. Porous Titanium Implants: A Review. Adv. Eng. Mater. 2018, 2018, 1–18. [Google Scholar] [CrossRef]
- Tande, A.J.; Patel, R. Prosthetic joint infection. Clin. Microbiol. Rev. 2014, 27, 302–345. [Google Scholar] [CrossRef]
- Smith, A.W. Biofilms and antibiotic therapy: Is there a role for combating bacterial resistance by the use of novel drug delivery systems? Adv. Drug Deliv. Rev. 2005, 57, 1539–1550. [Google Scholar] [CrossRef]
- Taheri, S.; Cavallaro, A.; Christo, S.N.; Smith, L.E.; Majewski, P.; Barton, M.; Hayball, J.D.; Vasiev, K. Substrate independent silver nanoparticle based antibacterial coatings. Biomaterials 2014, 35, 4601–4609. [Google Scholar] [CrossRef] [PubMed]
- Amin-Yavari, S.; Loozen, L.; Paganelli, F.L.; Bakhshandeh, S.; Lietaert, K.; Groot, J.A.; Fluit, A.C.; Boel, C.H.E.; Alblas, J.; Vogely, H.C.; et al. Antibacterial behavior of additively manufactured porous Titanium with nanotubular surfaces releasing Silver ions. ACS Appl. Mater. Interfaces 2016, 8, 17080–17089. [Google Scholar] [CrossRef] [PubMed]
- Jia, Z.; Li, M.; Xiu, P.; Xu, X.; Cheng, Y.; Zheng, Y.; Xi, T.; Wei, S.; Liu, Z. A novel cytocompatible, hierarchical porous Ti6Al4V scaffold with immobilized silver nanoparticles. Mater. Lett. 2015, 157, 143–146. [Google Scholar] [CrossRef]
- Rtimi, S.; Baghriche, O.; Pulgarin, C.; Ehiasarian, A.; Bandorf, R.; Kiwi, J. Comparison of HIPIMS sputtered Ag- and Cu-surfaces leading to accelerated bacterial inactivation in the dark. Surf. Coat. Technol. 2014, 250, 14–20. [Google Scholar] [CrossRef]
- Rtimi, S.; Sanjines, R.; Andrzejczuk, M.; Pulgarin, C.; Kulik, A.; Kiwi, J. Innovative transparent non-scattering TiO2 bactericide thin films inducing increased E. coli cell wall fluidity. Surf. Coat. Technol. 2014, 254, 333–343. [Google Scholar] [CrossRef]
- Rtimi, S.; Kiwi, J. Bactericide effects of transparent polyethylene photocatalytic films coated by oxides under visible light. Appl. Catal. B Environ. 2017, 213, 62–73. [Google Scholar] [CrossRef]
- Hasan, J.; Crawford, R.J.; Ivanova, E.P. Antibacterial surfaces: The quest for a new generation of biomaterials. Trends Biotechnol. 2013, 31, 295–304. [Google Scholar] [CrossRef]
- Bassegoda, A.; Ivanova, K.; Ramon, E.; Tzanov, T. Strategies to prevent the occurrence of resistance against antibiotics by using advanced materials. Appl. Microbiol. Biotechnol. 2018, 102, 2075–2089. [Google Scholar] [CrossRef] [Green Version]
- Moritz, M.; Geszke-Moritz, M. The newest achievements in synthesis, immobilization and practical applications of antibacterial nanoparticles. Chem. Eng. J. 2013, 228, 596–613. [Google Scholar] [CrossRef]
- Qiao, Y.; Liu, X. Biocompatible Coating. In Book Comprehensive Materials Processing; Hashmi, S., Ferreira, G., Van Tyne, C.J., Yilbas, B., Eds.; Elsevier: Amsterdam, The Netherlands, 2014; pp. 425–447. [Google Scholar] [CrossRef]
- McGilvray, K.C.; Waldorff, E.I.; Easley, J.; Seim, H.B.; Zhang, N.; Linovitz, R.J.; Ryaby, J.T.; Puttlitz, C.M. Evaluation of a polyetheretherketone (PEEK) titanium composite interbody spacer in an ovine lumbar interbody fusion model: Biomechanical, microcomputed tomographic, and histologic analyses. Spine, J. 2017, 17, 1907–1916. [Google Scholar] [CrossRef]
- Ouyang, L.; Zhao, Y.; Jin, G.; Lu, T.; Li, J.; Qiao, Y.; Ning, C.; Zhang, X.; Chu, P.K.; Liu, X. Influence of sulfur content on bone formation and antibacterial ability of sulfonated PEEK. Biomaterials 2016, 83, 115–126. [Google Scholar] [CrossRef] [PubMed]
- Najeeb, S.; Zafar, M.S.; Khurshid, Z.; Siddiqui, F. Applications of polyetheretherketone (PEEK) in oral implantology and prosthodontics. J. Prosthodon. Res. 2016, 60, 12–19. [Google Scholar] [CrossRef] [PubMed]
- Shuai, C.; Shuai, C.; Feng, P.; Gao, C.; Peng, S.; Yang, Y. Antibacterial capability, physicochemical properties, and biocompatibility of nTiO incorporated polymeric scaffolds. Polymers 2018, 10, 328. [Google Scholar] [CrossRef] [PubMed]
- Dominguez-Trujillo, C.; Peón, E.; Pavón, J.J.; Montealegre-Melendez, I.; Arevalo, C.; Galvan, J.C.; García-Moreno, F.; Torres, Y. Sol-gel deposition of hydroxyapatite coatings on porous titanium for biomedical applications. Surf. Coat. Technol. 2018, 333, 158–162. [Google Scholar] [CrossRef]
- Dominguez-Trujillo, C.; Ternero, F.; Rodriguez-Ortiz, J.A.; Pavón, J.J.; García-Couce, J.; Galvan, J.C.; García-Moreno, F.; Torres, Y. Improvement of the balance between a reduced stress shielding and bone ingrowth by bioactive coatings onto porous titanium substrates. Surf. Coat. Technol. 2018, 338, 32–37. [Google Scholar] [CrossRef]
- Dominguez-Trujillo, C.; Ternero, F.; Rodriguez-Ortiz, J.A.; Heise, S.; Boccaccini, A.R.; Lebrato, J.; Torres, Y. Bioactive coatings on porous titanium for biomedical applications. Surf. Coat. Technol. 2018, 349, 548–592. [Google Scholar] [CrossRef]
- Dominguez-Trujillo, C.; Beltrán, A.M.; Garvi, M.D.; Salazar-Moya, A.; Lebrato, J.; Hickey, D.J.; Rodriguez-Ortiz, J.A.; Kamm, P.H.; Lebrato, C.; García-Moreno, F.; et al. Bacterial behavior on coated porous titanium substrate for biomedical applications. Surf. Coat. Technol. 2019, 357, 896–902. [Google Scholar] [CrossRef]
- Civantos, A.; Domínguez, C.; Pino, R.J.; Setti, G.; Pavon, J.J.; Martínez-Campos, E.; Garcia-Garcia, F.J.; Rodriguez-Ortiz, J.A.; Allain, J.P.; Torres, Y. Designing bioactive porous titanium interfaces to balance mechanical properties and in vitro cells behavior towards increased osseointegration. Surf. Coat. Technol. 2019, 368, 162–174. [Google Scholar] [CrossRef]
- International Standard. ISO 13314: 2011 (E). Mechanical Testing of Metals—Ductility Testing—Compression Test. for Porous and Cellular Metals, Ref. Number ISO. 13314 (n.d.); International Organization for Standardization: Geneva, Switzerland, 2011; pp. 1–7. [Google Scholar]
- Oliver, W.C.; Pharr, G.M. Measurement of hardness and elastic modulus by instrumented indentation: Advances in understanding and refinements to methodology. J. Mater. Res. 2004, 19, 3–20. [Google Scholar] [CrossRef]
- Torres, Y.; Trueba, P.; Pavón, J.J.; Chicardi, E.; Kamm, P.; García-Moreno, F.; Rodríguez-Ortiz, J.A. Design, processing and characterization of titanium with radial graded porosity for bone implants. Mater. Des. 2016, 110, 179–187. [Google Scholar] [CrossRef]
- Lascano, S.; Arévalo, C.; Montealegre-Melendez, I.; Muñoz, S.; Rodríguez-Ortiz, J.A.; Trueba, P.; Torres, Y. Porous Titanium for biomedical applications: Evaluation of the Conventional powder metallurgy frontier and space-holder technique. Appl. Sci. 2019, 9, 982. [Google Scholar] [CrossRef]
- Teughels, W.; Van Assche, N.; Sliepen, I.; Quirynen, M. Effect of material characteristics and/or surface topography on biofilm development. Clin. Oral Implants Res. 2006, 17, 68–81. [Google Scholar] [CrossRef] [PubMed]
- Le Guéhennec, L.; Soueidan, A.; Layrolle, P.; Amouriq, Y. Surface treatments of titanium dental implants for rapid osseointegration. Dent. Mater. 2007, 23, 844–854. [Google Scholar] [CrossRef] [PubMed]
- Wennerberg, A.; Albrektsson, T. Effects of titanium surface topography on bone integration: A systematic review. Clin. Oral Implants Res. 2009, 20, 172–184. [Google Scholar] [CrossRef] [PubMed]
- Yin, X.Z.; Xiao, T.Q.; Nagia, A.; Yang, S.; Lu, X.-L.; Shao, Q.; He, Y.; York, P.; Zhang, J.-W. In situ 3D topographic and shape analysis by synchrotron radiation X-ray microtomography for crystal form identification in polymorphic mixtures. Sci. Rep. 2016, 6, 24763. [Google Scholar] [CrossRef] [PubMed]
- Graham, M.V.; Cady, N.C. Nano and microscale topographies for the prevention of bacterial surface fouling. Coatings 2014, 4, 37–59. [Google Scholar] [CrossRef]
- Whitehead, K.A.; Verran, J. The effect of surface topography on the retention of microorganisms. Food Bioprod. Process. 2006, 84, 253–259. [Google Scholar] [CrossRef]
- Nielsen, L.F. On strength of porous material: Simple systems and densified system. Mater. Struct. 1998, 31, 651–661. [Google Scholar] [CrossRef]
- Torres, Y.; García-Ostos, C.; Arevalo, C.; Gotor, F.J.; Pavón, J.J.; Trueba, P.; Rodriguez-Ortiz, J.A. Processing and characterization of surrogate nuclear materials with controlled radial porosity. J. Nucl. Sci. Technol. 2017, 54, 167–173. [Google Scholar] [CrossRef]
- Montero, J.F.; Tajiri, H.A.; Barra, G.M.; Fredel, M.C.; Benfatti, C.A.; Magini, R.S.; Pimienta, A.L.; Souza, J.C. Biofilm behavior on sulfonated poly (ether-ether-ketone)(sPEEK). Mater. Sci. Eng. C 2017, 70, 456–460. [Google Scholar] [CrossRef]
- Brum, R.S.; Monich, P.R.; Fredel, M.C.; Contri, G.; Ramoa, S.D.A.S.; Magini, R.S.; Benfatti, C.A.M. Polymer coatings based on sulfonated-poly-ether-ether-ketone films for implant dentistry applications. J. Mater. Sci. Mater. Med. 2018, 29, 132. [Google Scholar] [CrossRef] [PubMed]
- Yuan, B.; Cheng, Q.; Zhao, R.; Zhu, X.; Yang, X.; Yang, X.; Zhang, K.; Song, Y.; Zhang, X. Comparison of osteointegration property between PEKK and PEEK: Effects of surface structure and chemistry. Biomaterials 2018, 170, 116–126. [Google Scholar] [CrossRef] [PubMed]

| Samples | PT (%) | Confocal Laser | |||||
|---|---|---|---|---|---|---|---|
| Flat Surface | Pore Surface | ||||||
| Sa (µm) | Sq (µm) | Sz (µm) | Sa (µm) | Sq (µm) | Sz (µm) | ||
| Fully-Dense | 2.9 | 0.6 | 10.5 | 78.4 | - | ||
| (100–200) µm | 47.0 | 5.0 | 9.0 | 97.6 | 15.5 | 22.2 | 166.7 |
| (250–355) µm | 46.4 | 3.4 | 8.8 | 147.2 | 30.8 | 4.0 | 274.2 |
| (355–500) µm | 46.1 | 0.7 | 11.0 | 79.2 | 26.7 | 36.0 | 485.2 |
| Spacer Size (μm) | Surface/Volume (mm2/mm3) | Estimated | ||
|---|---|---|---|---|
| Flat Area (mm2) | Porous Area (mm2) | Volume (mm3) | ||
| 100–200 | 17.3 ± 1.3 | 54.0 ± 13.8 | 321.0 ± 44.8 | 18.6 ± 1.2 |
| 250–355 | 10.7 ± 0.8 | 59.9 ± 17.5 | 260.1 ± 29.6 | 24.3 ± 0.9 |
| 355–500 | 8.4 ± 0.6 | 50.8 ± 11.9 | 311.9 ± 29.9 | 37.1 ± 0.8 |
| Samples | Static Micro-Indentation Tests | Pseudo-Creep Behavior | |||
|---|---|---|---|---|---|
| hmax (µm) | Elastic Recovery | Plateau, Δh (µm) | Penetration Depth Rate (µm/s) × 10−4 | ||
| Absolute (µm) | Relative (%) | ||||
| Fully-dense | 4.3 ± 0.7 | 1.9 | 44 | 0.7 | 2.5 |
| (100–200) μm | 15 ± 4 | 7.1 | 47 | 0.8 | 1.4 |
| (355–500) μm | 7 ± 3 | 3.4 | 48 | 0.5 | 0.83 |
© 2019 by the authors. Licensee MDPI, Basel, Switzerland. This article is an open access article distributed under the terms and conditions of the Creative Commons Attribution (CC BY) license (http://creativecommons.org/licenses/by/4.0/).
Share and Cite
Beltrán, A.M.; Civantos, A.; Dominguez-Trujillo, C.; Moriche, R.; Rodríguez-Ortiz, J.A.; García-Moreno, F.; Webster, T.J.; Kamm, P.H.; Restrepo, A.M.; Torres, Y. Porous Titanium Surfaces to Control Bacteria Growth: Mechanical Properties and Sulfonated Polyetheretherketone Coatings as Antibiofouling Approaches. Metals 2019, 9, 995. https://doi.org/10.3390/met9090995
Beltrán AM, Civantos A, Dominguez-Trujillo C, Moriche R, Rodríguez-Ortiz JA, García-Moreno F, Webster TJ, Kamm PH, Restrepo AM, Torres Y. Porous Titanium Surfaces to Control Bacteria Growth: Mechanical Properties and Sulfonated Polyetheretherketone Coatings as Antibiofouling Approaches. Metals. 2019; 9(9):995. https://doi.org/10.3390/met9090995
Chicago/Turabian StyleBeltrán, Ana M., Ana Civantos, Cristina Dominguez-Trujillo, Rocío Moriche, José A. Rodríguez-Ortiz, Francisco García-Moreno, Thomas J. Webster, Paul H. Kamm, Andrea Mesa Restrepo, and Yadir Torres. 2019. "Porous Titanium Surfaces to Control Bacteria Growth: Mechanical Properties and Sulfonated Polyetheretherketone Coatings as Antibiofouling Approaches" Metals 9, no. 9: 995. https://doi.org/10.3390/met9090995






